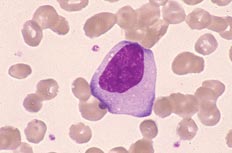

徢椺25
| 擭楊 | 10嵨戙 | |||
|---|---|---|---|---|
| 尰昦楌 | 敪擬丄婄柺晄椙 銪庮 乮亄乯丄娞庮 乮亅乯丄儕儞僷愡庮 乮亅乯 |
|||
| 寣塼妛強尒 | WBC乮/兪L乯 | 2,000 | RBC乮枩/兪L乯 | 360 |
| Hb乮g/dL乯 | 11.4 | Ht乮%乯 | 34.4 | |
| PLT乮枩/兪L乯 | 1.1 | MCV乮fL乯 | 95.6 | |
| MCH乮pg乯 | 31.7 | MCHC乮%乯 | 33.1 | |
| 寣塼憸乮%乯 | Blast條 | 1.0 | 丂 | |
| 崪悜強尒 | NCC乮枩/兪L乯 | 24.2 | MgK乮/兪L乯 | 0 |
| Blast條乮%乯 | 98.0 | 丂 | ||
| 惗壔妛強尒 | LDH 2,310 U/L | |||
| 昞柺宍幙 | CD13, CD33, CD14, CD11c, HLA-DR, TdT (亄乯 | |||
|
 |
|
|---|---|---|
| 乵枛徑寣亊1000.MG愼怓乶 夎媴條嵶朎偼N/C斾偑掅偔丄僋儘儅僠儞偼慹栐忬偱挊柧側妀彫懱偑傒傜傟傞(1%). |
乵崪悜亊400.MG愼怓乶 N/C斾偼掅偔丄夎媴條嵶朎偺憹壛偑傒傜傟傞. |
|
 |
 |
|
| 乵崪悜亊1000.MG愼怓乶 夎媴條嵶朎(98%)偼椶墌宍妀偱僋儘儅僠儞偼慇嵶栐忬偱挊柧側妀彫懱偑傒傜傟傞. |
乵崪悜亊1000.PO愼怓乶 夎媴條嵶朎偼PO愼怓偵堿惈偱偁傞. |
|
 |
||
| 乵崪悜亊1000.EST愼怓乶 夎媴條嵶朎偼兛-NA愼怓偵傃枬惈偺梲惈偱偁傞. |
||
丂惓夝丂丗丂2丂媫惈扨媴惈敀寣昦乮M5a)
奼戝偟偨宍懺夋憸偵偼丄夝愢偑娷傑傟偰偄傑偡丅
| 擭楊 | 10嵨戙 |
|---|---|
| 乣慜敪怣乣 | |
| 枛徑寣強尒偐傜 | 敀寣媴悢尭彮 乮2,000/兪L乯偺暘椶偵偰夎媴條嵶朎偼1%傒傜傟傞. |
| 崪悜強尒偐傜 | 崪悜偱偼丄戝宆偱N/C斾偺掅偄扨媴條嵶朎偺憹壛傪擣傔傞. NEC拞丄扨媴條嵶朎偼100%傪愯傔丄偦偺偆偪扨夎媴偼98%傪愯傔傞. |
| 嵶朎壔妛強尒偐傜 | 扨夎媴偼PO愼怓偵堿惈丄EST愼怓偵嫮梲惈傪掓偟丄NaF偵慾奞偝傟偨. EST愼怓偱偼兛-NB愼怓偵梓棻忬丄兛-NA愼怓偵傃枬惈梲惈偑傒傜傟傞. |
| 亂宍懺恌抐亃 | 崪悜偵偰扨媴宯偺憹壛丄偟偐傕扨夎媴偑80%埲忋傪帵偡偙偲傛傝M5a傪峫偊傞. EST愼怓偑梲惈丄NaF偵慾奞偝傟偨偙偲傛傝妋恌偵側傞. |
| 乣屻敪怣乣 | |
| 昞柺宍幙偐傜 | CD13, CD33, CD14, CD11c, HLA-DR, TdT乮亄乯 |
| 亂椪彴恌抐亃 | 崪悜偵偰扨媴宯嵶朎偑桪埵傪愯傔丄扨夎媴傪98%擣傔丄EST愼怓傗昞柺宍幙傛傝M5a偲恌抐偝傟偨. |
| WHO暘椶乮2022乯 | 夎媴偺暘壔抜奒偱掕媊偝傟傞AML乮AML, defining by differentiation乯 仚媫惈扨媴惈敀寣昦乮Acute monocytic leukemia乯乮M5a乯 |
